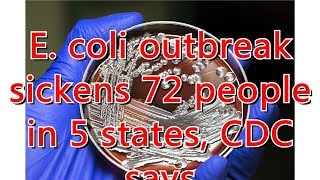

E. coli outbreak sickens 72 people in 5 states, CDC says video
Online izle ve mp4 mp3 formatlarinda yukle
Videonun muddeti: 1:50
E. coli outbreak sickens 72 people in 5 states, CDC says videosu mp4 ve mp3 yuklemek ucun hazirdir
Diqqet! Siz Mp4 yukle ve ya Mp3 yukle duymesine basdiqdan sonra eger sistem sizi reklam sehifesine atarsa o zaman derhal geri qayidib emeliyyati tekrar edin ve faylin yuklemek ucun hazir olmasini gozleyin
Videodan Mp4 Yukle
Videodan Mp3 Yukle-1
Videodan Mp3 Yukle-2
Oxshar Axtarishlar
Mystery E. coli outbreak sickens 72 people in 5 states, CDC says
E. coli outbreak sickens 72 people in 5 states, CDC says
Mystery E. Coli Outbreak Sickens 72 People In 5 States, Including Virginia, CDC Says
E. coli outbreak sickens 72 people in 5 states, CDC says
Mystery E. Coli Outbreak Sickens 72 People In 5 States, Including Virginia, CDC Says
CDC reports 72 sick from E. coli outbreak
CDC: E. Coli Outbreak Expands
Doctor: E. Coli outbreak likely to get worse
E. coli outbreak sickens 96 people across 5 states, CDC says
Video Mp4 Mp3Azwap.Biz
Azwap.Biz 2021-2023